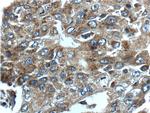
CCNDBP1 Antibody in Immunohistochemistry (Paraffin) (IHC (P))

Search
Proteintech
CCNDBP1 Polyclonal Antibody
{{$productOrderCtrl.translations['antibody.pdp.commerceCard.promotion.promotions']}}
{{$productOrderCtrl.translations['antibody.pdp.commerceCard.promotion.viewpromo']}}
{{$productOrderCtrl.translations['antibody.pdp.commerceCard.promotion.promocode']}}: {{promo.promoCode}} {{promo.promoTitle}} {{promo.promoDescription}}. {{$productOrderCtrl.translations['antibody.pdp.commerceCard.promotion.learnmore']}}
产品信息
12363-1-AP
种属反应
已发表种属
宿主/亚型
分类
类型
抗原
偶联物
形式
浓度
规格
纯化类型
保存液
内含物
保存条件
运输条件
产品详细信息
Immunogen sequence: MASATAPAA AVPTLASPLE QLRHLAEELR LLLPRVRVGE AQETTEEFNR EMFWRRLNEA AVTVSREATT LTIVFSQLPL PSPQETQKFC EQVHAAIKAF IAVYYLLPKD QGITLRKLVR GATLDIVDGM AQLMEVLSVT PTQSPENNDL ISYNSVWVAC QQMPQIPRDN KAAALLMLTK NVDFVKDAHE EMEQAVEECD PYSGLLNDTE ENNSDNHNHE DDVLGFPSNQ DLYWSEDDQE LIIPCLALVR ASKACLKKIR MLVAENGKKD QVAQLDDIVD ISDEISPSVD DLALSIYPPM CHLTVRINSA KLVSVLKKAL EITKASHVTP QPEDSWIPLL INAIDHCMNR IKELTQSELE L (1-360 aa encoded by BC009689)
靶标信息
This gene was identified by the interaction of its gene product with Grap2, a leukocyte-specific adaptor protein important for immune cell signaling. The protein encoded by this gene was shown to interact with cyclin D. Transfection of this gene in cells was reported to reduce the phosphorylation of Rb gene product by cyclin D-dependent protein kinase, and inhibit E2F1-mediated transcription activity. This protein was also found to interact with helix-loop-helix protein E12 and is thought to be a negative regulator of liver-specific gene expression. Two alternatively spliced variants, which encode distinct isoforms, have been reported.
仅用于科研。不用于诊断过程。未经明确授权不得转售。
生物信息学
蛋白别名: CCNDBP1; cyclin D-type binding-protein 1; Cyclin-D1-binding protein 1; D-type cyclin-interacting protein 1; Grap2 and cyclin-D-interacting protein; Human homolog of Maid; Id-related protein; Maternal Id-like protein; maternal inhibition of differentiation; SSEC-8; Stage specific embryonic cDNA-8 protein; unnamed protein product
基因别名: AU022347; CCNDBP1; DIP1; GCIP; HHM; Maid; SECC-8; SSEC-8
UniProt ID: (Human) O95273, (Rat) Q5BK06, (Mouse) Q3TVC7
Entrez Gene ID: (Human) 23582, (Rat) 362201, (Mouse) 17151